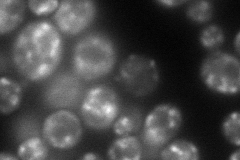
YGL137W
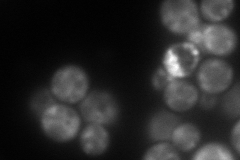
YGL137W
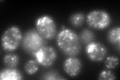
YGL137W
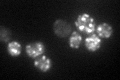
YGL137W

View description
Essential beta'-coat protein of the COPI coatomer, involved in ER-to-Golgi and Golgi-to-ER transport; contains WD40 domains that mediate cargo selective interactions; 45% sequence identity to mammalian beta'-COP
Localization:
Intensity:
Fold change:
Significance:
-
C’ GFP library in SD

punctate136.74 -
N' NOP1pr-GFP in SD
punctate135.255 -
N' TEF2pr-mCherry in SD
punctate172.152 -
N' NATIVEpr-GFP in SD

missing0 -
N' TEF2pr-VC and Cyto-VN in SD

cytosol59.7601 -
C’ GFP library in SD+DTT
punctate177.051.29No -
C’ GFP library in SD+H2O2

punctate125.810.92No -
C’ GFP library in Starvation Media
punctate130.230.95No -
C’ GFP library on the background of Pup2-DaMP

punctate -
C’ GFP library on the background of CCT mutant

punctate140.7251.02912No
